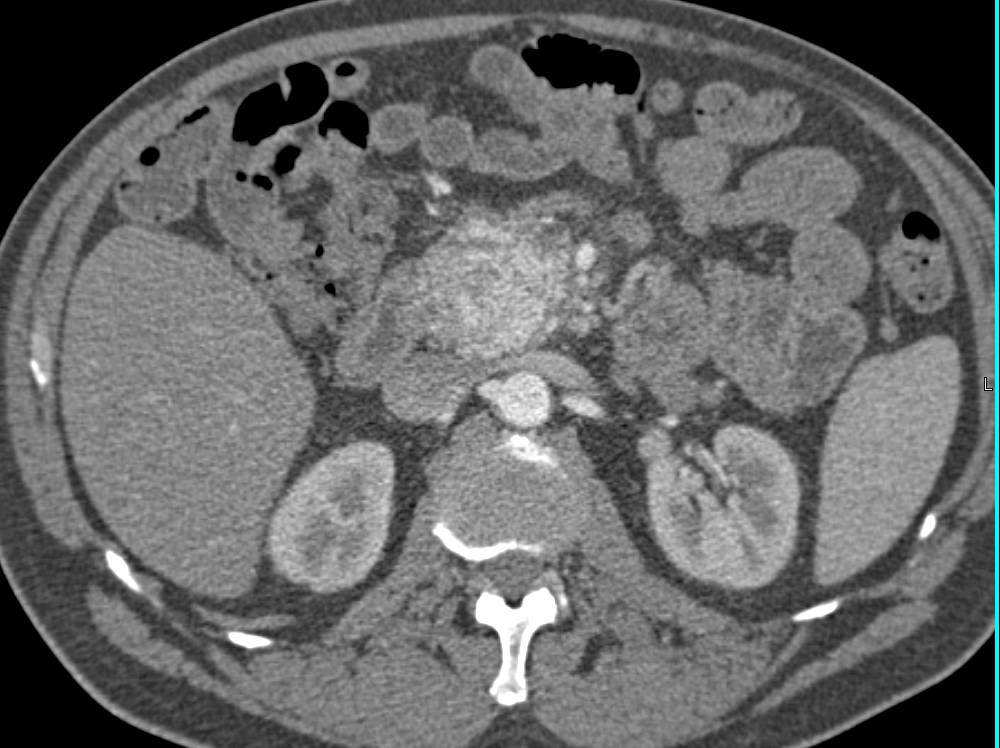

- 4
- 7
- ,
- 0
- 3
- 7
To Quiz Yourself: Select OFF by clicking the button to hide the diagnosis & additional resources under the case.
Quick Browser: Select ON by clicking the button to hide the additional resources for faster case review.
CASE NUMBER
3,010
Diagnosis
Pancreatic Cancer with Arterial and Venous Invasion and Liver Metastases
THIS IS CASE
3,010
OF
6,125